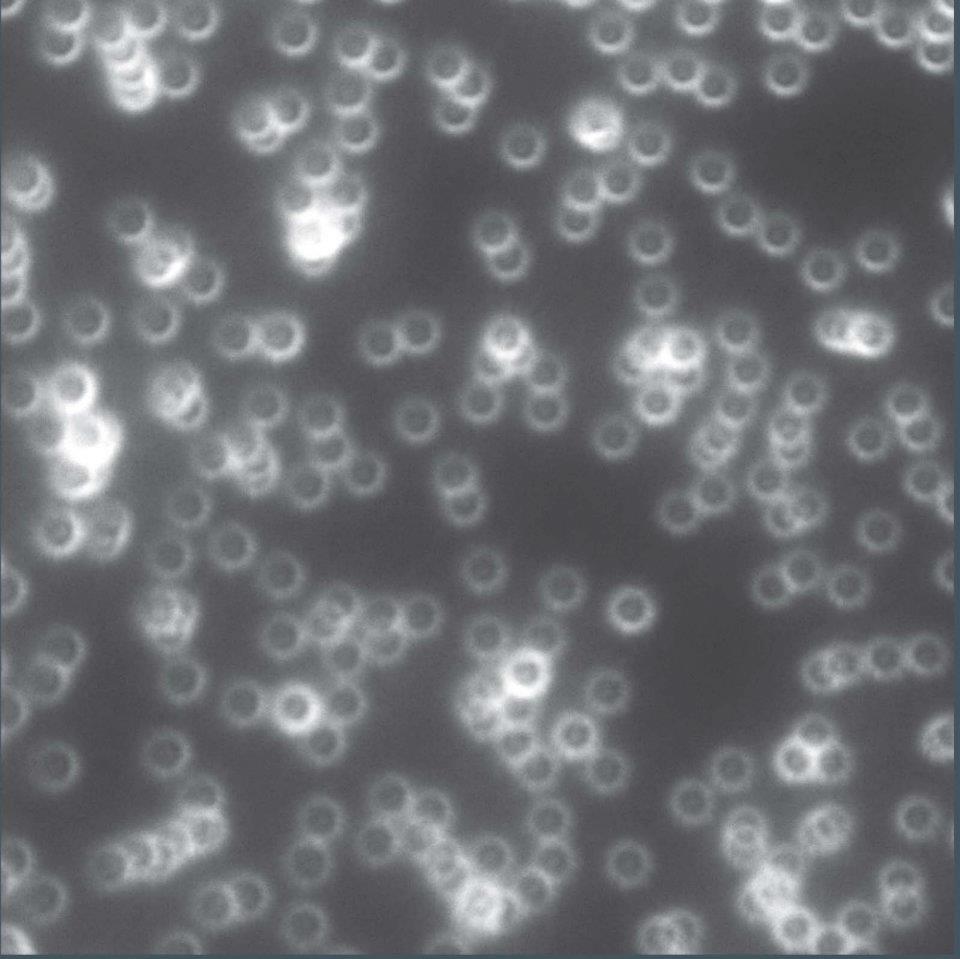
Distinction<br />
Zeiss LSM 710 Confocal Microscope

CURATED BY
Kathryn Faith
WHEN
July 6 - July 6
WHERE
View Gallery
1
/
10

In this image, pollen grains from Croton hirtus (rushfoil), Mabea occidentalis (Mabea) and Agropyron repens (quackgrass) provide a glimpse of the extraordinary morphological variety of pollen. Their shapes and surface textures were revealed using cutting-edge fluorescence microscopy at the IGB. The shape of pollen grains from different plants can be so distinct that pollen identification based on structure has been used in forensic investigations, archaeological studies, and to confirm the purity of monofloral honeys.

Image provided by Luke Mander, Surangi Punyasena Lab
Research funded by the National Science Foundation
In this image, pollen grains from Croton hirtus (rushfoil), Mabea occidentalis (Mabea) and Agropyron repens (quackgrass) provide a glimpse of the extraordinary morphological variety of pollen. Their shapes and surface textures were revealed using cutting-edge fluorescence microscopy at the IGB. The shape of pollen grains from different plants can be so distinct that pollen identification based on structure has been used in forensic investigations, archaeological studies, and to confirm the purity of monofloral honeys.

This image shows microscopic structures inside a leaf: chloroplasts in light blue, and mitochondria, which convert sugar into forms of usable energy, in a range of colors (yellow to brown) according to their size. Mitochondria react very quickly to changes in the cellular environment by clumping together or dispersing throughout the cell in response to changes in light, temperature, and rate of photosynthesis in the chloroplasts. Research to understand how mitochondria respond to climate change has implications for accurate prediction of future food supply and ecosystem function.

This image shows the musculature of the developing hind leg of an African clawed frog, Xenopus laevis. Researchers hope that studies of limb development will significantly enable scientists and physicians to develop better alternative therapies to repair traumatic limb injuries instead of relying on amputation, so that people can maintain a functional limb despite tragic accidents.

The curling ribbon in this image is a representation of a protein’s crystal structure. The image was produced as part of an investigation into one of nature's most efficient catalysts, orotidine 5'-monophosphate decarboxylase (OMPDC). OMPDC helps produce one of the building blocks of RNA. Understanding how proteins like OMPDC function can extend our knowledge of what makes life possible.

This image represents an intuitive way to visualize relationships between sequence and function across a large collection of related proteins. Software tools that organize this type of information make it easier to put large data sets to practical use.

Specially engineered substances called instructive biomaterials have the potential to induce regeneration of or replace damaged tissues and organs. The microscopic scaffolding in this image is designed to aid the regrowth of blood vessels. Better models are needed to elucidate the important mechanisms associated with regeneration processes.

Crop scientists are trying to identify and “improve” plant species that can be used to manufacture biofuels on a global scale, with more efficiency and less waste. This cross-section of a stem of Miscanthus grass, when compared to similar images of other grasses, shows the anatomical differences between Miscanthus and other potential biofuel crops. Knowing these differences could affect the ways that researchers attempt to improve these crops.

Just like animals, plants must “breathe;” they take in air and release respiratory by-products through pores called stomata. This image conveys the three-dimensional shape of the surface of an Arabidopsis leaf, showing the distribution and shape of individual stomata.

Some species of nematodes (roundworms) are pests that penetrate and feed on roots of switchgrass. Scientists study nematodes because they are the most abundant multicellular animals on the face of the earth. They occur literally everywhere—in soil and decaying matter from the poles to the tropics, in all forms of plant life, and in the bodies of almost all animals, from humans to insects.

This image is part of a computer simulation of the process that forms travertine near geothermal hot springs. It describes the interplay between fluid flow, chemical precipitation and possible microbe community dynamics. Discovering how the activities of living organisms can shape geophysical processes is important to understanding many phenomena, and could even help us detect the signatures of life on other planets, such as Mars.

The resiliency of social networks is an important determinant of health and well-being in human society. Like humans, honey bees live in complex societies characterized by extensive communication, strong division of labor, and striking resiliency. The researchers who produced this image use tiny barcodes, machine vision, and computer models to identify and track individual honey bees (colored squares) and to monitor their social interactions (yellow lines). One focus of this project is to identify differences between bees that relate to societal resiliency.

Insect brains, like the honey bee brain shown here, are very different in shape from human brains. Despite that, bee and human brains have a lot in common, including many of the genes and neurochemicals they rely on in order to function. The bright green dye marks the presence of tyrosine hydroxylase, a gene that allows the brain to produce dopamine. Dopamine is involved in many important functions, such as the ability to experience pleasure.
Like the previous similar image, this image allows researchers to test a microscope’s point spread function, a measure of the limits of resolution of the instrument. The relative clarity of the microscopic fluorescent beads shown here demonstrate the quality of the microscope.

This image is a cross-section of a stem of the perennial grass Miscanthus. The lacy green structure that comprises the stem gains its strength from a complex sugar called cellulose. The conversion of cellulose (the main component of plant cell walls) into fuel is a primary focus of biofuel research. This process makes use of the entire plant rather than only a portion.

This second image of travertine from the Anio Novus aqueduct shows the naturally-occurring fluorescence of different layers of the rock. The fluorescence could be produced by the remains of microbes living within the layers of sediment, the minerals of the rock itself, or both.

By the end of this century, atmospheric CO2 levels are predicted to double. Plants use CO2 to produce sugar during photosynthesis, and release CO2 as they respire. With research that produces images like this one, researchers monitor how increased CO2 changes the balance between photosynthetic and respiratory processes. In the leaf cell shown here, chloroplasts are labeled with red, mitochondria that contribute to respiration are labeled with green, and other fluid inside the cell is labeled with blue.
Zeiss LSM 700 Confocal Microscope
In this image, pollen grains from Croton hirtus (rushfoil), Mabea occidentalis (Mabea) and Agropyron repens (quackgrass) provide a glimpse of the extraordinary morphological variety of pollen. Their shapes and surface textures were revealed using cutting-edge fluorescence microscopy at the IGB. The shape of pollen grains from different plants can be so distinct that pollen identification based on structure has been used in forensic investigations, archaeological studies, and to confirm the purity of monofloral honeys.

This image, related to the previous one, takes a closer look at what happens in a developing spermatid. In a DHA-deficient mouse, the many small vesicles of acrosin (shown here in red) are not able to join together to form the acrosome, and instead remain scattered.

Initiated in 1896 by the University of Illinois, the Illinois selection experiment has produced populations of corn with extreme differences in kernel protein concentration. The experiment reveals how artificial selection alters the regulation of gene expression. Researchers used the intensity of fluorescence in images like the ones on the left to measure protein concentration and localization. Understanding the biological mechanisms controlling the nutritional quality of corn and other cereal grains will help meet the food needs of a growing world population.

This image shows a Nuclear Magnetic Resonance (NMR) spectrum, a representation of how atoms within a molecule respond to a magnetic field. NMR spectra are very important for discovering the structure of organic compounds and proteins. They are also very useful in studying the interactions between drug molecule and target protein, information that can then be used for the structure-based drug design.
Floral Fingerprints
Scientist Collaborator
Luke Mander
Surangi Punyasena Lab
Instrument
Zeiss Apotome, Zeiss LSM 710 NLO
Funding Agency
Research funded by the National Science Foundation
Original Imaging



Image Rights
Images not for public use without permission from the Carl R. Woese Institute for Genomic Biology.
Share
Floral Fingerprints
Scientist Collaborator
Luke Mander
Surangi Punyasena Lab
Instrument
Zeiss Apotome, Zeiss LSM 710 NLO
Funding Agency
Research funded by the National Science Foundation
Original Imaging



Image Rights
Images not for public use without permission from the Carl R. Woese Institute for Genomic Biology.
Share
Spring growth, fall colors
Scientist Collaborator
R. J. Cody Markelz
Andrew Leakey Lab
Instrument
Spinning Disk Confocal and Imaris 3D visualization
Funding Agency
Research funded by the National Science Foundation
Original Imaging



Image Rights
Images not for public use without permission from the Carl R. Woese Institute for Genomic Biology.
Share
Macho frog
Scientist Collaborator
Nandini Goswami
Jo Ann Cameron Lab
Instrument
QImaging Retiga 2000R Fast 1394 camera
Funding Agency
Research funded by the W.M. Keck Foundation and the National Science Foundation
Original Imaging



Image Rights
Images not for public use without permission from the Carl R. Woese Institute for Genomic Biology.
Share
Spark of life
Scientist Collaborator
B. McKay Wood
John Gerlt Lab
Instrument
Chimera software
Funding Agency
Research funded by the National Institutes of Health
Original Imaging



Image Rights
Images not for public use without permission from the Carl R. Woese Institute for Genomic Biology.
Share
Nearest neighbors
Scientist Collaborator
Jason Bouvier
John Gerlt Lab
Instrument
Cytoscape software
Funding Agency
Research funded by the National Institutes of Health
Original Imaging



Image Rights
Images not for public use without permission from the Carl R. Woese Institute for Genomic Biology.
Share
Guideposts for growth
Scientist Collaborator
Aurora Turgeon
Ryan Bailey Lab
Instrument
Zeiss LSM 710 Confocal Microscope
Funding Agency
Research funded by the National Science Foundation, the Alfred P. Sloan Foundation, and the 3M Corporation
Original Imaging



Image Rights
Images not for public use without permission from the Carl R. Woese Institute for Genomic Biology.
Share
Apex
Scientist Collaborator
Brandon James
Stephen Moose Lab
Instrument
Zeiss LSM 710 Confocal Microscope
Funding Agency
Research funded by the Energy Biosciences Institute
Original Imaging



Image Rights
Images not for public use without permission from the Carl R. Woese Institute for Genomic Biology.
Share
Breathe
Scientist Collaborator
Mayandi Sivaguru
Core Facilities
Instrument
Zeiss LSM 710 Confocal Microscope
Funding Agency
Research funded by the Institute for Genomic Biology
Original Imaging



Image Rights
Images not for public use without permission from the Carl R. Woese Institute for Genomic Biology.
Share
Pioneering pests
Scientist Collaborator
Tesfamariam Mekete Mengistu
Michael Gray Lab
Instrument
Zeiss Axion A1 Imager Version 4.0
Funding Agency
Research funded by British Petroleum and the Energy Biosciences Institute
Original Imaging



Image Rights
Images not for public use without permission from the Carl R. Woese Institute for Genomic Biology.
Share
(De)constructing the steps
Scientist Collaborator
John Veysey
Nigel Goldenfeld
Nicholas Guttenberg
Nigel Goldenfeld Lab and Bruce Fouke Lab
guava
Instrument
Blender and proprietary simulations
Funding Agency
Research funded by the National Science Foundation
Original Imaging



Image Rights
Images not for public use without permission from the Carl R. Woese Institute for Genomic Biology.
Share
Bee to bee
Scientist Collaborator
Tim Gernat
Gene Robinson Lab
Instrument
Canon EOS-1Ds Mark III
Funding Agency
Research funded by the National Institutes of Health and the Christopher Foundation
Original Imaging



Image Rights
Images not for public use without permission from the Carl R. Woese Institute for Genomic Biology.
Share
Cognition writ small
Scientist Collaborator
Matthew McNeill
Gene Robinson Lab
Instrument
Zeiss LSM 700 Confocal Microscope
Funding Agency
Research funded by the National Institutes of Health
Original Imaging



Image Rights
Images not for public use without permission from the Carl R. Woese Institute for Genomic Biology.
Share
Distinction
Scientist Collaborator
Mayandi Sivaguru
Core Facilities
Instrument
Zeiss LSM 710 Confocal Microscope
Funding Agency
Research funded by the Institute for Genomic Biology
Original Imaging



Image Rights
Images not for public use without permission from the Carl R. Woese Institute for Genomic Biology.
Share
Portal to a greener world
Scientist Collaborator
Mayandi Sivaguru
Core Facilities
Instrument
Zeiss LSM 710 Confocal Microscope
Funding Agency
Research funded by the Institute for Genomic Biology
Original Imaging



Image Rights
Images not for public use without permission from the Carl R. Woese Institute for Genomic Biology.
Share
What remains
Scientist Collaborator
Duncan Keenan-Jones
Mayandi Sivaguru
Glenn Fried
Bruce Fouke
Bruce Fouke Lab
Instrument
Zeiss LSM 710 Confocal Microscope
Funding Agency
Research funded by the Total Oil Company
Original Imaging



Image Rights
Images not for public use without permission from the Carl R. Woese Institute for Genomic Biology.
Share
Opposing forces
Scientist Collaborator
R. J. Cody Markelz
Andrew Leakey Lab
Instrument
Zeiss LSM 700 Confocal Microscope and Imaris 3D Rendering Software
Funding Agency
Research funded by National Science Foundation
Original Imaging



Image Rights
Images not for public use without permission from the Carl R. Woese Institute for Genomic Biology.
Share
New Developments
Scientist Collaborator
Manuel Roqueta-Rivera
Manabu Nakamura Lab
Instrument
Zeiss LSM 700 Confocal Microscope
Funding Agency
Research funded by CONACyT Fellowship from Mexico, USDA, National Institute of Food and Agriculture, and Royal DSM
Original Imaging



Image Rights
Images not for public use without permission from the Carl R. Woese Institute for Genomic Biology.
Share
Dust in the wind
Scientist Collaborator
Tim Abbott
Manabu Nakamura Lab
Instrument
Zeiss LSM 700 Confocal Microscope
Funding Agency
Research funded by Martek Biosciences Inc. and the United States Department of Agriculture
Original Imaging



Image Rights
Images not for public use without permission from the Carl R. Woese Institute for Genomic Biology.
Share
Illini crop
Scientist Collaborator
Christine Lucas
Stephen Moose Lab
Instrument
Zeiss LSM 710 Confocal Microscope
Funding Agency
Research funded by the United States Department of Agriculture and the National Science Foundation
Original Imaging



Image Rights
Images not for public use without permission from the Carl R. Woese Institute for Genomic Biology.
Share
Good vibrations
Scientist Collaborator
Xudong Guan
Core Facilities
Instrument
Agilent 600 MHz NMR
Funding Agency
Research funded by the Institute for Genomic Biology
Original Imaging



Image Rights
Images not for public use without permission from the Carl R. Woese Institute for Genomic Biology.
Share
Special Thanks
Champaign businessman Doug Nelson, President of BodyWork Associates, first proposed the idea that became Art of Science, and his continued efforts to support the exhibit made its realization possible. The IGB is also grateful to James Barham of Barham Benefit Group and [co][lab] founder Matt Cho for hosting the annual exhibit.